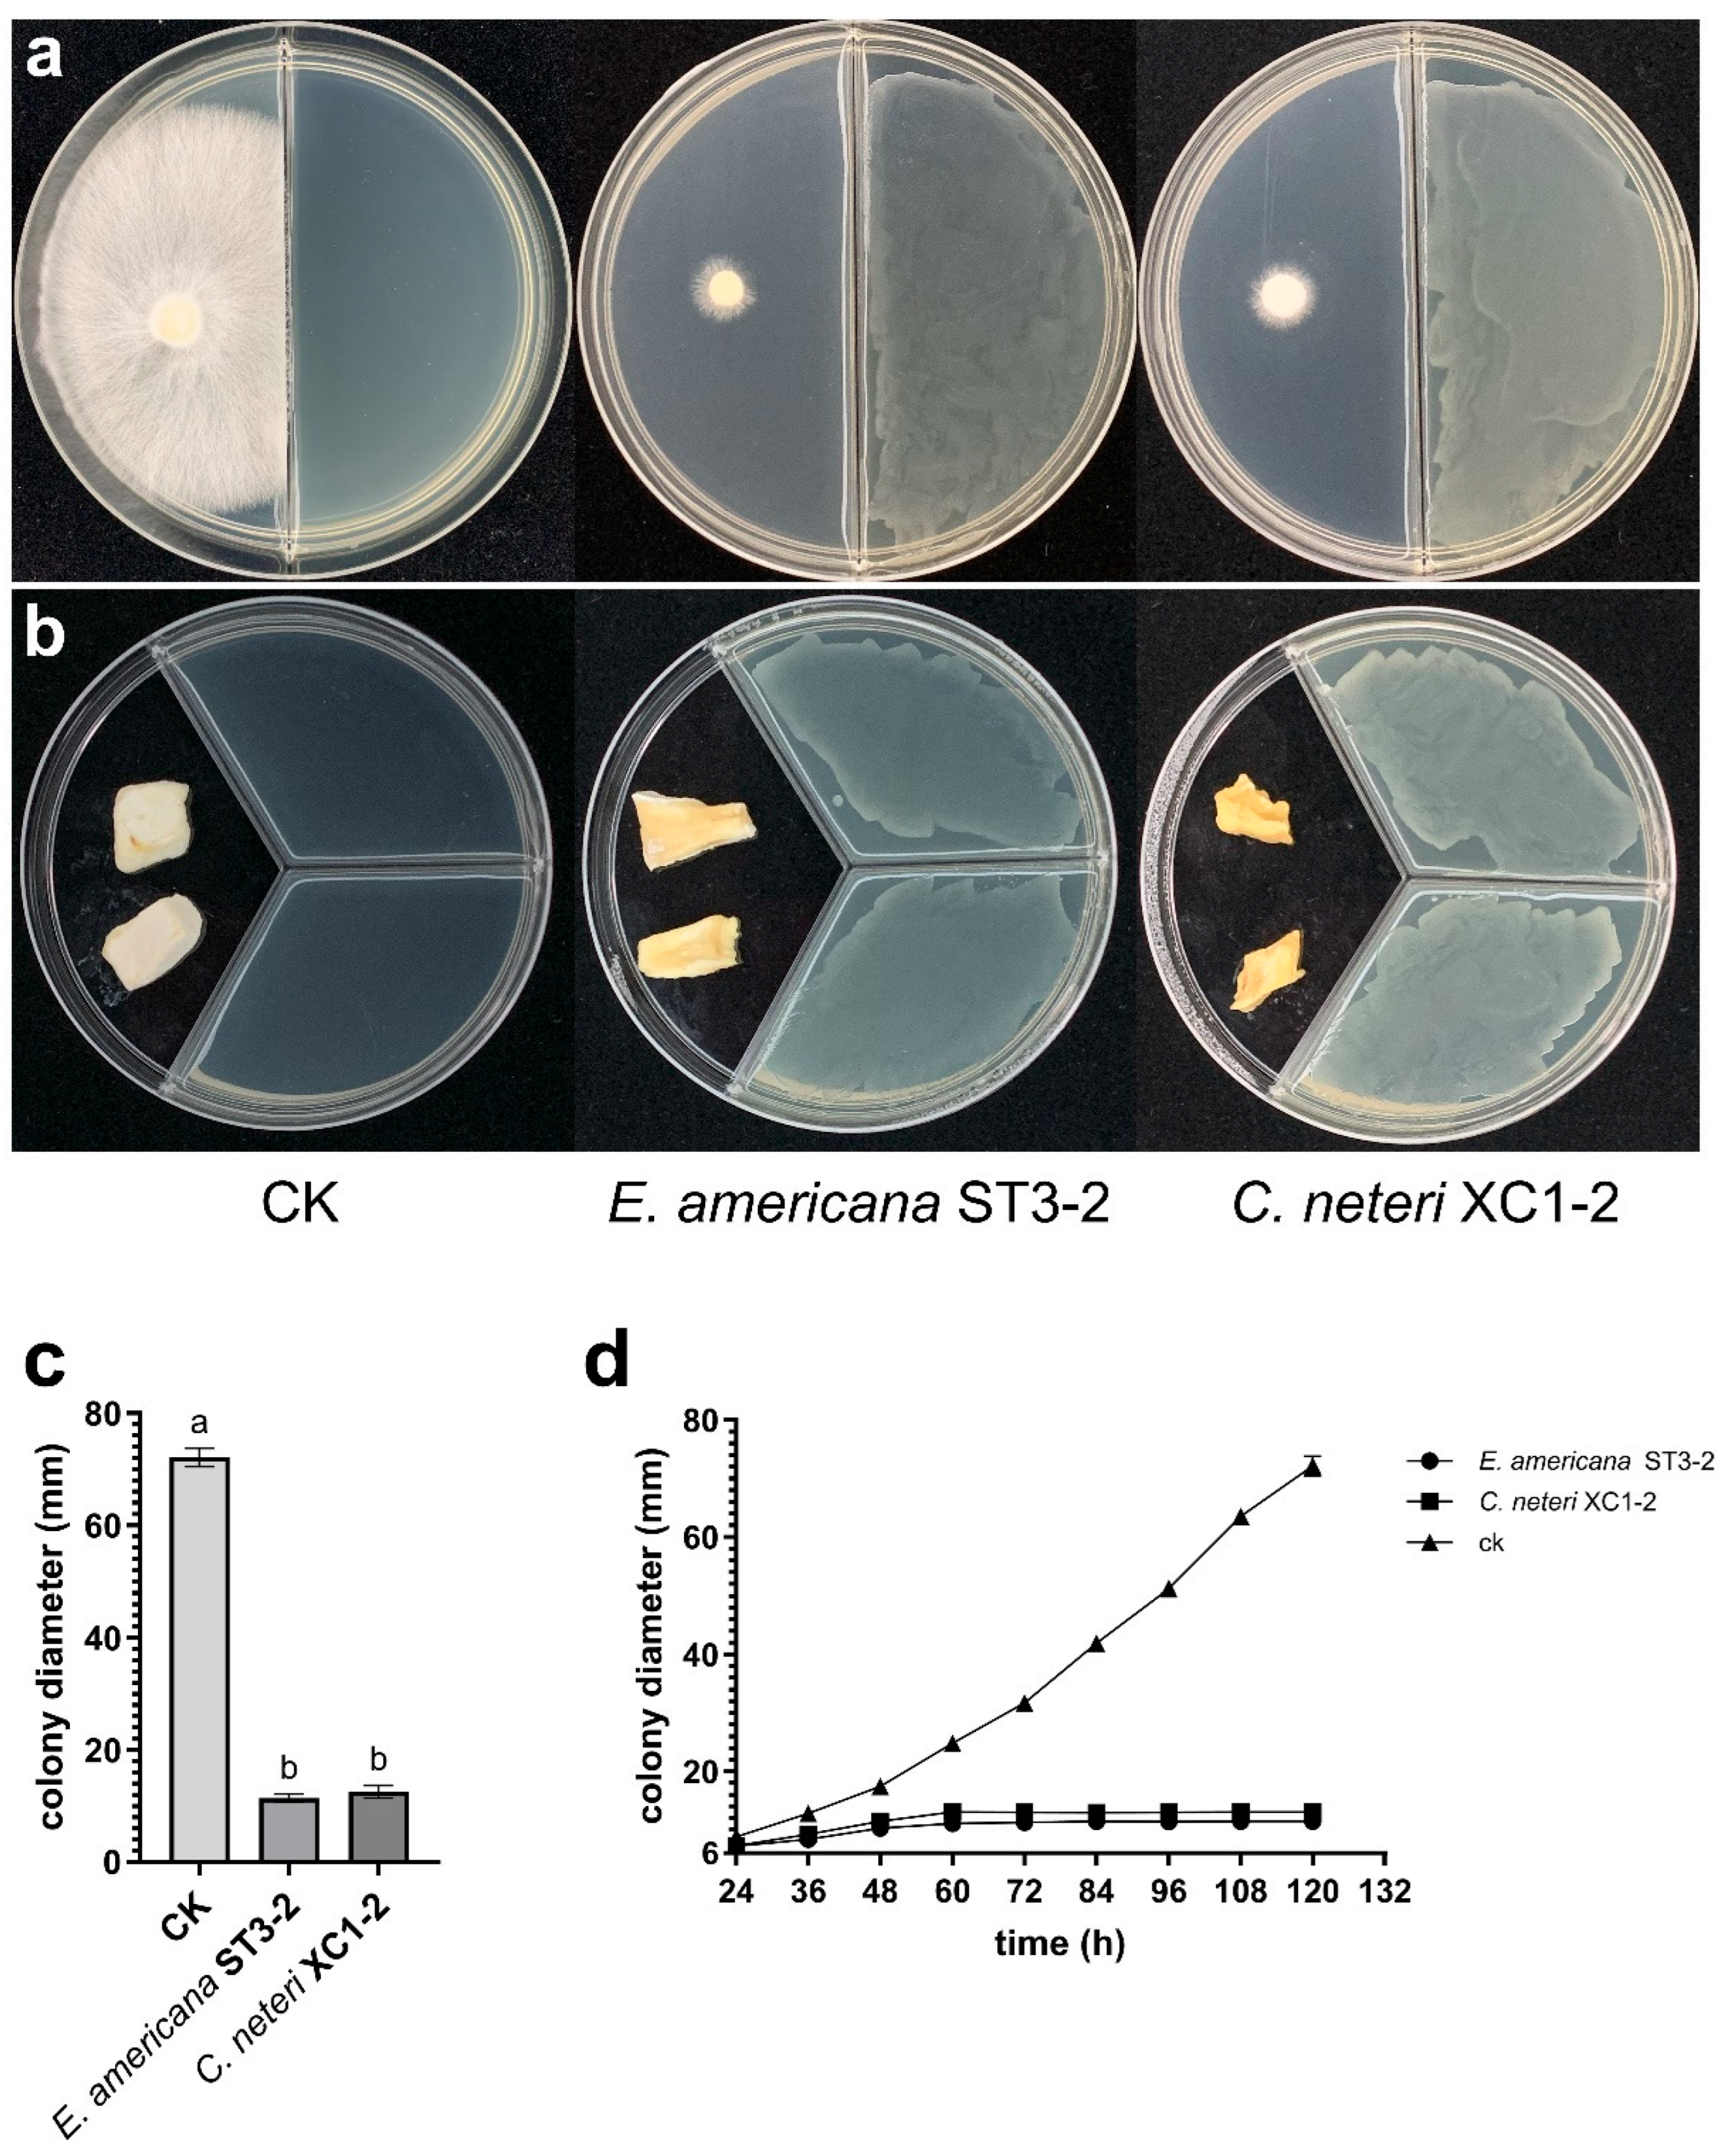
Toxins 17 00449 g002

Toxicity of Volatile Organic Compounds Produced by Pathogens Ewingella americana and Cedecea neteri Associated with Pleurotus pulmonarius
Abstract
1. Introduction
2. Results
2.1. Pathogen Isolation and Pathogenicity Test
2.2. Pathogen Identification
2.3. Effect of VOCs from E. americana and C. neteri on P. pulmonarius
2.4. GC-MS Analysis of VOCs from E. americana and C. neteri on P. pulmonarius
2.5. Toxicity of VOCs on P. pulmonarius
3. Discussion
4. Conclusions
5. Materials and Methods
5.1. Pathogen Isolation
5.2. Pathogen Analysis
5.3. Pathogenicity Identification
5.4. Bioassay of VOCs by E. americana and C. neteri In Vitro
5.5. HS-SPME-GC-MS Analysis of VOCs
5.6. Toxicity Bioassays of Individual VOCs on P. pulmonarius
5.7. Statistical Analysis
Supplementary Materials
Author Contributions
Funding
Institutional Review Board Statement
Informed Consent Statement
Data Availability Statement
Conflicts of Interest
References
- Chen, L.L.; Xu, S.M.; Chen, J.Q.; Zhang, M.; Qiu, M.M.; Jiang, Y.J.; Chen, B.Z. Transcriptome Sequencing Analysis of the Effects of 1-MCP and Ethephon Treatments on the Storage Quality of Pleurotus pulmonarius. Sci. Hortic. 2024, 338, 113721. [Google Scholar] [CrossRef]
- Huang, Z.X.; Liang, X.S.; Wang, Y.F.; Mo, M.Q.; Qiu, Y.; Liu, B. Ginger Blotches on Agaricus bisporus Due to Monoacetylphloroglucinol Production by the Pathogen Pseudomonas ‘gingeri’. Pest Manag. Sci. 2023, 79, 5197–5207. [Google Scholar] [CrossRef]
- Rakhmonov, U.; Soatov, T. Harmful Competitors and Diseases of Pleurotus ostreatus and Their Control Measures. E3S Web Conf. 2023, 389, 03101. [Google Scholar] [CrossRef]
- Taparia, T.; Hendrix, E.; Hendriks, M.; Krijger, M.; de Boer, W.; van Der Wolf, J. Comparative Studies on the Disease Prevalence and Population Dynamics of Ginger Blotch and Brown Blotch Pathogens of Button Mushrooms. Plant Dis. 2021, 105, 542–547. [Google Scholar] [CrossRef]
- Huang, Z.X.; Nie, Y.L.; Huang, Y.Y.; Liu, L.Z.; Liu, B. Elucidating the Role of Monoacetylphloroglucinol in the Pathogenicity of Pseudomonas ‘gingeri’ against Agaricus bisporus. Pest Manag. Sci. 2024, 80, 3526–3539. [Google Scholar] [CrossRef] [PubMed]
- Wang, G.Z.; Liu, C.G.; Shen, N.; Wu, Y.Z.; Bian, Y.B.; Xiao, Y. Differential Analyses of Morphology and Transcription from Oyster Mushroom Pleurotus ostreatus Response to Brown Blotch Disease. Sci. Hortic. 2024, 331, 113141. [Google Scholar] [CrossRef]
- Liu, Z.H.; Zhao, Y.T.; Sossah, F.L.; Okorley, B.A.; Amoako, D.G.; Liu, P.B.; Sheng, H.Y.; Li, D.; Li, Y. Characterization, Pathogenicity, Phylogeny, and Comparative Genomic Analysis of Pseudomonas tolaasii Strains Isolated from Various Mushrooms in China. Phytopathology 2022, 112, 521–534. [Google Scholar] [CrossRef] [PubMed]
- Bruno, G.L.; De Corato, U.; Rana, G.L.; De Luca, P.; Pipoli, V.; Lops, R.; Scarola, L.; Mannerucci, F.; Piscitelli, L.; Cariddi, C. Suppressiveness of White Vinegar and Steam-Exploded Liquid Waste against the Causal Agents of Pleurotus eryngii Yellowing. Crop Prot. 2015, 70, 61–69. [Google Scholar] [CrossRef]
- Wang, Q.; Xu, R.P.; Guo, M.P.; Shen, N.; Chuaoen, P.; Qiu, K.X.; Bian, Y.B.; Xiao, Y. Serial Transcriptional Changes of Flammulina filiformis (Winter Mushroom) Mycelia Infected by Pseudomonas migulae. Sci. Hortic. 2022, 297, 110965. [Google Scholar] [CrossRef]
- Huang, Z.X.; Huang, Y.Y.; Nie, Y.L.; Liu, B. Biological Characteristics of Two Pathogens Causing Brown Blotch in Agaricus bisporus and the Toxin Identification of Cedecea neteri. Phytopathol. Res. 2024, 6, 21. [Google Scholar] [CrossRef]
- Liu, Z.L.; Zhou, S.Y.; Zhang, W.L.; Wu, S.J.; Chen, X.F.; Wang, X.G.; Hu, H.J.; Chen, Q. First Report of Cedecea neteri Causing Yellow Rot Disease in Pleurotus pulmonarius in China. Plant Dis. 2021, 105, 1189. [Google Scholar] [CrossRef]
- Yan, J.J.; Liu, Y.Y.; Wang, R.Q.; Mukhtar, I.; Liu, F.; Lin, Z.Y.; Jiang, Y.J.; Xie, B.G. First Report of Cedecea neteri Causing Yellow Sticky Disease in Flammulina velutipes in China. Plant Dis. 2019, 103, 1014–1015. [Google Scholar] [CrossRef]
- Sugendra Kumar, V. Antimicrobial Activity of Silver Nanoparticles for the Control of Microbial Spoilage of Grey Oyster Mushroom (Pleurotus pulmonarius). Ph.D. Dissertation, Universiti Malaya, Kuala Lumpur, Malaysia, 2021. Available online: https://www.proquest.com/dissertations-theses/antimicrobial-activity-silver-nanoparticles/docview/3143984806/se-2 (accessed on 10 June 2025).
- Bellettini, M.B.; Bellettini, S.; Fiorda, F.A.; Pedro, A.C.; Bach, F.; Fabela-Morón, M.F.; Hoffmann-Ribani, R. Diseases and Pests Noxious to Pleurotus spp. Mushroom Crops. Rev. Argent. Microbiol. 2018, 50, 216–226. [Google Scholar] [CrossRef] [PubMed]
- Yang, Y.; Liu, Q.; Zhang, Z.X.; Dong, C.H. First Report of Bacterial Brown Rot Disease Caused by Ewingella americana on Cultivated Naematelia aurantialba in China. Plant Dis. 2023, 107, 2513. [Google Scholar] [CrossRef]
- Na, W.J.; Luo, H.; Yu, J.M. First Report of Bacterial Brown Rot Disease on Shiitake Mushroom (Lentinula edodes) Caused by Ewingella americana in Korea. J. Plant Pathol. 2021, 103, 1325–1326. [Google Scholar] [CrossRef]
- Kim, Y.N.; Lee, D.H.; Yu, J.M. Brown Rot Caused by Ewingella americana on King Oyster Mushroom (Pleurotus eryngii) in Korea. J. Plant Pathol. 2023, 105, 327. [Google Scholar] [CrossRef]
- Liu, Z.H.; Sossah, F.L.; Li, Y.; Fu, Y.P. First Report of Ewingella americana Causing Bacterial Brown Rot Disease on Cultivated Needle Mushroom (Flammulina velutipes) in China. Plant Dis. 2018, 102, 2633. [Google Scholar] [CrossRef]
- Dang, H.; Kong, Q.Q.; Winchester, W.; Wan, X.; Lei, Y.; Zhang, H.S.; Zhao, Y.; Liu, X.Y.; Xu, B.B.; Zhang, B.S.; et al. Isolation, Identification, and Pathogenic Effects of Trichoderma spp. from Auricularia auricula. Adv. Compos. Hybrid Mater. 2023, 6, 96. [Google Scholar] [CrossRef]
- Lo Cantore, P.; Giorgio, A.; Iacobellis, N.S. Bioactivity of Volatile Organic Compounds Produced by Pseudomonas tolaasii. Front. Microbiol. 2015, 6, 1082. [Google Scholar] [CrossRef] [PubMed]
- Ghasemi, S.; Harighi, B.; Mojarrab, M.; Azizi, A. Response of Pseudomonas tolaasii, the Causal Agent of Mushroom Brown Blotch Disease, to the Volatile Compounds Produced by Endofungal Bacteria. BioControl 2021, 66, 421–432. [Google Scholar] [CrossRef]
- Müller, H.E.; Fanning, G.R.; Brenner, D.J. Isolation of Ewingella americana from Mollusks. Curr. Microbiol. 1995, 31, 287–290. [Google Scholar] [CrossRef] [PubMed]
- Lu, N.; Yan, J.; Wang, W.K. Identification and Pollution Source Analysis of Pleurotus pulmonarius Blight Disease Caused by Ewingella americana. Acta Edulis Fungi 2023, 30, 92–101. [Google Scholar] [CrossRef]
- Inglis, P.W.; Peberdy, J.F. Isolation of Ewingella americana from the Cultivated Mushroom, Agaricus bisporus. Curr. Microbiol. 1996, 33, 334–337. [Google Scholar] [CrossRef]
- Reyes, J.E.; Venturini, M.E.; Oria, R.; Blanco, D. Prevalence of Ewingella americana in Retail Fresh Cultivated Mushrooms (Agaricus bisporus, Lentinula edodes, and Pleurotus ostreatus) in Zaragoza (Spain). FEMS Microbiol. Ecol. 2004, 47, 291–296. [Google Scholar] [CrossRef]
- Lo Cantore, P.; Lazzaroni, S.; Coraiola, M.; Dalla Serra, M.; Cafarchia, C.; Evidente, A.; Iacobellis, N.S. Biological Characterization of White Line-Inducing Principle (WLIP) Produced by Pseudomonas reactans NCPPB1311. Mol. Plant Microbe Interact. 2006, 19, 1113–1120. [Google Scholar] [CrossRef]
- Shirata, A. Production of Volatile Components by Pseudomonas tolaasii and Their Toxic Activity. Jpn. J. Phytopathol. 1996, 62, 185–193. [Google Scholar] [CrossRef]
- Li, S.N.; Chen, Q.; Wang, H.; Huang, L.L. Volatile Metabolites and Toxin Activity of Valsa mali. Acta Agric. Boreali-Occident. Sin. 2018, 27, 692–698. [Google Scholar] [CrossRef]
- Soler-Rivas, C.; Arpin, N.; Olivier, J.-M.; Wichers, H.J. The Effects of Tolaasin, the Toxin Produced by Pseudomonas tolaasii, on Tyrosinase Activities and the Induction of Browning in Agaricus bisporus Fruiting Bodies. Physiol. Mol. Plant Pathol. 1999, 55, 21–28. [Google Scholar] [CrossRef]
- Shirata, A.; Sugaya, K.; Takasugi, M.; Monde, K. Isolation and Biological Activity of Toxins Produced by a Japanese Strain of Pseudomonas tolaasii, the Pathogen of Bacterial Rot of Cultivated Oyster Mushroom. Jpn. J. Phytopathol. 1995, 61, 493–502. [Google Scholar] [CrossRef][Green Version]
- Zhao, F.Q.; Wang, P.; Lucardi, R.D.; Su, Z.S.; Li, S.Y. Natural Sources and Bioactivities of 2,4-Di-Tert-Butylphenol and Its Analogs. Toxins 2020, 12, 35. [Google Scholar] [CrossRef]
- Dharni, S.; Sanchita; Maurya, A.; Samad, A.; Srivastava, S.K.; Sharma, A.; Patra, D.D. Purification, Characterization, and In Vitro Activity of 2,4-Di-tert-butylphenol from Pseudomonas monteilii PsF84: Conformational and Molecular Docking Studies. J. Agric. Food Chem. 2014, 62, 6138–6146. [Google Scholar] [CrossRef] [PubMed]
- Fan, K.; Yu, Y.N.; Hu, Z.; Qian, S.A.; Zhao, Z.H.; Meng, J.J.; Zheng, S.M.; Huang, Q.W.; Zhang, Z.Q.; Nie, D.X.; et al. Antifungal Activity and Action Mechanisms of 2,4-Di-tert-butylphenol against Ustilaginoidea virens. J. Agric. Food Chem. 2023, 71, 17723–17732. [Google Scholar] [CrossRef]
- Bennett, J.W.; Inamdar, A.A. Are Some Fungal Volatile Organic Compounds (VOCs) Mycotoxins? Toxins 2015, 7, 3785–3804. [Google Scholar] [CrossRef] [PubMed]
- Sheikh, T.M.M.; Zhou, D.M.; Haider, M.S.; Hussain, S.; Wang, N.; Chen, S.Q.; Zhao, Y.S.; Wen, X.; Feng, H.; Wang, X.Y.; et al. Volatile Organic Compounds from Pythium oligandrum Play a Role in Its Parasitism on Plant-Pathogenic Pythium myriotylum. Appl. Environ. Microbiol. 2023, 89, e0203622. [Google Scholar] [CrossRef]
- Ulloa, P.A.; Valencia, A.L.; Olivares, D.; Poblete-Morales, M.; Silva-Moreno, E.; Defilippi, B.G. Antifungal Effect of Volatile Organic Compounds (VOCs) Released from Antarctic Bacteria under Postharvest Conditions. Food Packag. Shelf Life 2023, 39, 101160. [Google Scholar] [CrossRef]
- Corre, M.-H.; Mercier, A.; Bouteiller, M.; Khalil, A.; Ginevra, C.; Depayras, S.; Dupont, C.; Rouxel, M.; Gallique, M.; Grac, L.; et al. Bacterial Long-Range Warfare: Aerial Killing of Legionella pneumophila by Pseudomonas fluorescens. Microbiol. Spectr. 2021, 9, e0040421. [Google Scholar] [CrossRef]
- Zou, X.R.; Wei, Y.Y.; Jiang, S.; Xu, F.; Wang, H.F.; Zhan, P.P.; Shao, X.F. ROS Stress and Cell Membrane Disruption Are the Main Antifungal Mechanisms of 2-Phenylethanol Against Botrytis cinerea. J. Agric. Food Chem. 2022, 70, 14468–14479. [Google Scholar] [CrossRef]
- Gomaa, A.E.-R.F.; Tao, J.; Liang, S.-Y.; Liu, J.-Q.; Yang, S.; Shi, X.-Q.; El-Sayed, M.H.; Xing, K.; Qin, S. Biocontrol of Postharvest Soft Rot Caused by Rhizopus stolonifer in Sweet Potatoes Using Volatile Organic Compounds from Actinomycete Nocardiopsis dassonvillei MI-S24. Food Control 2025, 111, 111359. [Google Scholar] [CrossRef]
- Ren, L.; Zhou, J.B.; Yin, H.; Qin, N.; Yao, F.T.; Ma, D.L.; Zhao, X.J. Antifungal Activity and Control Efficiency of Endophytic Bacillus velezensis ZJ1 Strain and Its Volatile Compounds Against Alternaria solani and Botrytis cinerea. J. Plant Pathol. 2022, 104, 575–589. [Google Scholar] [CrossRef]
- Delgado, N.; Olivera, M.; Cádiz, F.; Bravo, G.; Montenegro, I.; Madrid, A.; Fuentealba, C.; Pedreschi, R.; Salgado, E.; Besoain, X. Volatile Organic Compounds (VOCs) Produced by Gluconobacter cerinus and Hanseniaspora osmophila Displaying Control Effect against Table Grape-Rot Pathogens. Antibiotics 2021, 10, 663. [Google Scholar] [CrossRef]
- Rey-Serra, P.; Mnejja, M.; Monfort, A. Inheritance of Esters and Other Volatile Compounds Responsible for the Fruity Aroma in Strawberry. Front. Plant Sci. 2022, 13, 959155. [Google Scholar] [CrossRef]
- Krüger, R.L.; Dallago, R.M.; Nascimento Filho, I.; Di Luccio, M. Study of Odor Compounds in Gaseous Effluents Generated During Production of Poultry Feather and Viscera Meal Using Headspace Solid Phase Microextraction. Environ. Monit. Assess. 2009, 158, 355–363. [Google Scholar] [CrossRef]
- Martos, P.A.; Pawliszyn, J. Sampling and Determination of Formaldehyde Using Solid-Phase Microextraction with On-Fiber Derivatization. Anal. Chem. 1998, 70, 2311–2320. [Google Scholar] [CrossRef]
- Rodigast, M.; Mutzel, A.; Iinuma, Y.; Haferkorn, S.; Herrmann, H. Characterisation and Optimisation of a Method for the Detection and Quantification of Atmospherically Relevant Carbonyl Compounds in Aqueous Medium. Atmos. Meas. Tech. Discuss. 2015, 8, 2409–2416. [Google Scholar] [CrossRef]
- Yu, X.; Sun, Y.R.; Shen, X.; Li, W.C.; Cai, H.Y.; Guo, S.; Sun, Z.H. Effect of Different Isolation Sources of Lactococcus lactis subsp. lactis on Volatile Metabolites in Fermented Milk. Food Chem. 2024, 21, 101224. [Google Scholar] [CrossRef]
- Han, T.-L.; Yang, Y.; Zhang, H.; Law, K.P. Analytical Challenges of Untargeted GC-MS-Based Metabolomics and the Critical Issues in Selecting the Data Processing Strategy. F1000Research 2017, 6, 967. [Google Scholar] [CrossRef]
- Galkiewicz, J.P.; Kellogg, C.A. Cross-kingdom amplification using bacteria-specific primers: Complications for studies of coral microbial ecology. Appl. Environ. Microbiol. 2008, 74, 7828–7831. [Google Scholar] [CrossRef]
- Pham, H.N.; Ohkusu, K.; Mishima, N.; Noda, M.; Shah, M.M.; Sun, X.; Hayashi, M.; Ezaki, T. Phylogeny and species identification of the family Enterobacteriaceae based on dnaJ sequences. Diagn. Microbiol. Infect. Dis. 2007, 58, 153–161. [Google Scholar] [CrossRef]
- Yamamoto, S.; Harayama, S. PCR amplification and direct sequencing of gyrB genes with universal primers and their application to the detection and taxonomic analysis of Pseudomonas putida strains. Appl. Environ. Microbiol. 1995, 61, 1104–1109. [Google Scholar] [CrossRef]
- Kemmler, E.; Lemfack, M.C.; Goede, A.; Gallo, K.; Toguem, S.M.T.; Ahmed, W.; Millberg, I.; Preissner, S.; Piechulla, B.; Preissner, R. mVOC 4.0: A Database of Microbial Volatiles. Nucleic Acids Res. 2025, 53, D1692–D1696. [Google Scholar] [CrossRef]

| Compound | Formula | CAS No. | C. neteri XC1-2 | E. americana ST3-2 | ||
|---|---|---|---|---|---|---|
| Prob. (%) | RPA (%) | Prob. (%) | RPA (%) | |||
| Isoamyl acetate | C7H14O2 | 123-92-2 | 89.34 | 5.55 | 86.60 | 10.50 |
| Isoamyl alcohol | C5H12O | 123-51-3 | - | - | 53.90 | 7.18 |
| 2-heptanone | C7H14O | 110-43-0 | 71.52 | 1.32 | 51.28 | 2.44 |
| 2-nonanone | C9H18O | 821-55-6 | 82.41 | 15.86 | 76.43 | 14.72 |
| 2-nonanol | C9H20O | 628-99-9 | 61.93 | 4.36 | - | - |
| 2-phenylethanol | C8H10O | 60-12-8 | 81.63 | 2.83 | 80.07 | 7.12 |
| 2-decanone | C10H20O | 693-54-9 | 71.32 | 2.16 | - | - |
| 2-undecanone | C11H22O | 112-12-9 | 81.76 | 32.71 | 66.57 | 2.08 |
| 1,3-di-tert-butylbenzene | C14H22 | 1014-60-4 | 70.36 | 0.85 | - | - |
| 2-ethylhexan-1-ol | C8H18O | 104-76-7 | 54.68 | 0.37 | 50.19 | 1.21 |
| Dimethyl trisulfide | C2H6S3 | 3658-80-8 | 96.45 | 0.11 | - | - |
| 2-heptanol | C7H16O | 543-49-7 | 50.96 | 0.20 | - | - |
| 2-undecanol | C11H24O | 1653-30-1 | 55.60 | 2.42 | 51.36 | 1.44 |
| 2-dodecanone | C12H24O | 6175-49-1 | 77.61 | 0.85 | - | - |
| 2-tridecanone | C13H26O | 593-08-8 | 75.98 | 9.37 | - | - |
| 2,4-di-tert-butylphenol | C14H22O | 96-76-4 | 71.59 | 3.86 | 63.06 | 11.93 |
| Concentration (μg/L) | 2,4-DTBP | 2-Phenylethanol | 2-Nonanol | 2-Undecanol | 2-Nonanone | 2-Undecanone | 2-Tridecanone |
|---|---|---|---|---|---|---|---|
| Mean ± SD (%) | Mean ± SD (%) | Mean ± SD (%) | Mean ± SD (%) | Mean ± SD (%) | Mean ± SD (%) | Mean ± SD (%) | |
| 0 | 0 ± 0 a | 0 ± 0 a | 0 ± 0 a | 0 ± 0 a | 0 ± 0 a | 0 ± 0 a | 0 ± 0 a |
| 5 | 97.82 ± 0.67 b | ||||||
| 10 | 99.88 ± 0.07 c | ||||||
| 25 | 99.92 ± 0.06 c | 67.11 ± 1.47 b | 70.55 ± 1.56 b | 97.76 ± 1.37 b | 46.32 ± 0.29 b | 16.75 ± 2.98 b | 27.61 ± 3.42 b |
| 50 | 99.91 ± 0.02 c | 87.05 ± 3.19 c | 99.53 ± 0.12 c | 99.27 ± 0.36 bc | 54.92 ± 2.84 c | 45.38 ± 3.52 c | 35.52 ± 2.81 c |
| 100 | 99.17 ± 0.13 d | 99.88 ± 0.07 c | 99.86 ± 0.06 c | 66.32 ± 3.87 d | 79.07 ± 1.74 d | 86.88 ± 1.06 d | |
| 200 | 99.79 ± 0.11 d | 99.88 ± 0.08 c | 99.86 ± 0.09 c | 88.5 ± 1.66 e | 99.88 ± 0.06 e | 98.24 ± 0.64 e |
Disclaimer/Publisher’s Note: The statements, opinions and data contained in all publications are solely those of the individual author(s) and contributor(s) and not of MDPI and/or the editor(s). MDPI and/or the editor(s) disclaim responsibility for any injury to people or property resulting from any ideas, methods, instructions or products referred to in the content. |
© 2025 by the authors. Licensee MDPI, Basel, Switzerland. This article is an open access article distributed under the terms and conditions of the Creative Commons Attribution (CC BY) license (https://creativecommons.org/licenses/by/4.0/).
Share and Cite
Wei, Z.; Wang, Y.; Qiu, J.; Nie, Y.; Wang, L.; Liu, B. Toxicity of Volatile Organic Compounds Produced by Pathogens Ewingella americana and Cedecea neteri Associated with Pleurotus pulmonarius. Toxins 2025, 17, 449. https://doi.org/10.3390/toxins17090449
Wei Z, Wang Y, Qiu J, Nie Y, Wang L, Liu B. Toxicity of Volatile Organic Compounds Produced by Pathogens Ewingella americana and Cedecea neteri Associated with Pleurotus pulmonarius. Toxins. 2025; 17(9):449. https://doi.org/10.3390/toxins17090449
Chicago/Turabian StyleWei, Zhiyuan, Yifan Wang, Jieheng Qiu, Yulu Nie, Lian Wang, and Bin Liu. 2025. "Toxicity of Volatile Organic Compounds Produced by Pathogens Ewingella americana and Cedecea neteri Associated with Pleurotus pulmonarius" Toxins 17, no. 9: 449. https://doi.org/10.3390/toxins17090449
APA StyleWei, Z., Wang, Y., Qiu, J., Nie, Y., Wang, L., & Liu, B. (2025). Toxicity of Volatile Organic Compounds Produced by Pathogens Ewingella americana and Cedecea neteri Associated with Pleurotus pulmonarius. Toxins, 17(9), 449. https://doi.org/10.3390/toxins17090449

